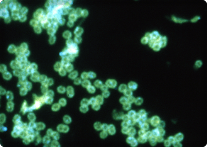

りんきんかんせんしょう
淋菌感染症(淋病)
りんきんかんせんしょう
淋菌感染症(淋病)
淋菌感染症(淋病)とは

image:Wikipedia
淋菌感染症(淋病)は、淋菌(Neisseria gonorrhoeae)による感染症で、主に男性は尿道炎、女性は子宮頸管炎を引き起こします。
淋菌感染症は、性器クラミジア感染症と並んで、頻度の高い性感染症であり、淋菌感染者との1回の性行為により感染する確率は30%と非常に高いのが特徴です。性行動の多様化を反映して、咽頭や直腸感染などの性器以外の感染例が増加しています。
また近年では、淋菌の薬耐性化が顕著で、多剤耐性化が進んでいます。
淋菌感染症は、性器クラミジア感染症と並んで、頻度の高い性感染症であり、淋菌感染者との1回の性行為により感染する確率は30%と非常に高いのが特徴です。性行動の多様化を反映して、咽頭や直腸感染などの性器以外の感染例が増加しています。
また近年では、淋菌の薬耐性化が顕著で、多剤耐性化が進んでいます。
image:Wikipedia
感染経路
淋菌は、高温にも低温にも弱く、増殖するためには酸素が少なくて二酸化炭素が多い環境が必要なので、通常の環境では生存することができません。
そのため、性感染症として、人から人へ感染するのが主な感染経路です。
そのため、性感染症として、人から人へ感染するのが主な感染経路です。
主な感染経路

性行為によるパートナーからの感染
性交渉・アナルセックス・オーラルセックス
※ 淋菌感染症は、性器から咽頭(のど)、咽頭から性器への感染が知られています。
性交渉・アナルセックス・オーラルセックス
※ 淋菌感染症は、性器から咽頭(のど)、咽頭から性器への感染が知られています。

産道感染
子宮頸管にクラミジアが感染していると、分娩時に産道を通る胎児にクラミジアが感染します。
その結果、出生後に結膜炎や肺炎を起こします。
子宮頸管にクラミジアが感染していると、分娩時に産道を通る胎児にクラミジアが感染します。
その結果、出生後に結膜炎や肺炎を起こします。

淋菌感染者との無防備な性交渉は淋菌感染の可能性が高くなります。淋菌感染者との1回の性交渉により感染する確率は30%と非常に高いのが特徴です。

症状と潜伏期間

男性の、淋菌性尿道炎におけるクラミジアの合併頻度は20~30%になります。


- 尿道のかゆみ
- 排尿時の痛みや灼熱感
- 黄色くどろどろとした膿が多く出る
感染後2~7日の潜伏期間を経て、尿道炎症状である排尿痛や尿道分泌物が見られます。

- 陰嚢の脹大
- 陰嚢の疼痛
淋菌性尿道炎が治療されないと、尿道内の淋菌が管内性に上行し、精巣上体炎を起こします。
はじめは片側性ですが、治療されなければ両側性となり、治療後に無精子症を生じる場合があります。
はじめは片側性ですが、治療されなければ両側性となり、治療後に無精子症を生じる場合があります。

淋菌性卵管炎を治療しないで放置すると、クラミジアと同様に、異所性妊娠(子宮外妊娠)や不妊症の原因になります。


- おりものの増加
- 不正出血や下腹部痛
男性と比べて無症状例が多いため、潜伏期ははっきりとしません。そのため、感染に気づかず、男性の淋菌感染症の感染源となります。

- 下腹部痛
- 微熱
- 不正出血

- 排尿痛
- 排尿困難
子宮頸管炎と併発することもあります。

- 下腹部痛
- 発熱
- 不正出血
子宮付属器炎(卵管炎・卵巣炎)、骨盤腹膜炎の疾患は、単独でも発症しますが、しばしば併発します。
検査について
◎検査の種類と方法
淋菌の検出法は、グラム染色標本の検鏡、培養法、核酸増幅法などがあります。
| 検査法 | 検査原理 | 特色 |
|---|---|---|
|
検査法
グラム染色・鏡検法
|
検査原理
尿道分泌物または腟分泌物をグラム染色した後、顕微鏡で観察する。グラム陰性双球菌が観察されれば淋菌と強く推定される。
|
特色
迅速診断として極めて有用で、尿道炎における診断には必須である。子宮頸管、咽頭、直腸など淋菌以外の他の細菌が多く存在する部位では推奨されない。
|
|
検査法
淋菌培養法
|
検査原理
尿道分泌物または腟分泌物を選択培地等を用いて培養する。
|
特色
薬剤感受性試験(病原体に有効な薬剤を見つける検査)が実施できるので、多剤耐性淋菌の増加に伴い積極的に推奨される。検査結果が出るまでに一定の時間を要する。
|
|
検査法
核酸増幅法 (遺伝子検査) |
検査原理
リアルタイムPCR法、SDA法、TMA法などで検体中の淋菌が有する、遺伝子を増幅させて検出する。
|
特色
リアルタイムPCR法やSDA法、TMA法は、クラミジアとの同時検査が可能である。遺伝子を増幅させて検出するため感度が高いが、遺伝子増幅阻害物質の存在で偽陰性になることがある。また、淋菌の生死にかかわらず検出してしまうため、治療後の判定には注意が必要である。
|
※当所では、リアルタイム PCRで検査を行っております。
予防
女性では無症状例が多く、治療しないまま淋菌に持続的に感染している人もいるため、性交渉の際にコンドームを使用することが淋菌の感染拡大を防止する有効な手段です。
性的感染からの予防
性交渉の際は、コンドームを正しく使用する。
産道感染からの予防
妊娠中に淋菌感染(淋病)がわかった場合には適切な薬剤で治療を行うことで、産道感染を防ぐことができます。

※淋菌やクラミジアなどの性感染症に感染すると、腟の中の粘膜が炎症を起こし、他の性感染症にかかるリスクが高まります。
治療法
淋菌の治療には抗菌剤(セフトリアキソン、スペクチノマイシン、セフィキシムなど)が用いられます。
● 静脈注射・単回投与(セフトリアキソン) / 筋肉注射・単回投与(スペクチノマイシン)
● 抗菌剤の経口服用(セフィキシムなど)
服用期間 :
おおよそ1~ 7 日間 (抗菌剤の種類によって異なります)
治癒判定 : 抗菌薬に耐性を持った淋菌(薬剤耐性淋菌)は、投与しても治療効果が出ない抗菌薬があるため、 完治したことが確認できるまで、医師の判断に従うことが必要です。
なお、女性の性器淋菌感染症は、治療失敗例を放置すると不妊症の原因となります。
医師が治癒と判定するまでは、しっかりと治療を行いましょう。
治癒判定 : 抗菌薬に耐性を持った淋菌(薬剤耐性淋菌)は、投与しても治療効果が出ない抗菌薬があるため、 完治したことが確認できるまで、医師の判断に従うことが必要です。
なお、女性の性器淋菌感染症は、治療失敗例を放置すると不妊症の原因となります。
医師が治癒と判定するまでは、しっかりと治療を行いましょう。

薬剤耐性菌とは
淋菌を含めた微生物は、抗生物質などの抗菌薬に接触して自ら薬剤の耐性機能を獲得したり、外部から薬剤を不活化できる遺伝子を獲得すると、特定の薬剤に対して抵抗力(薬剤耐性)を持つようになり、薬剤が効かなくなったり、効きにくくなったりします。こうした、薬剤に対する抵抗力を持った菌を 薬剤耐性菌と呼びます。※薬剤耐性菌を作らない為に、症状が改善されても自己判断で薬の服用を中止せず、医師の処方に従い最後まで服用することが大切です。
淋菌についてのQ&A
- 最近の淋菌には、テトラサイクリンやニューキノロンは効果がないというのは本当ですか。
-
テトラサイクリンおよび、ニューキノロン系薬剤については、耐性率が高く、ほとんど効果が認められません。
第三世代経口セフェム系薬剤に対しても、耐性化が進んでおり、今現在淋菌に有効な薬剤としては、セフトリアキソン(ロセフィン)・セフォジジム(ケニセフ)・スペクチノマイシン(トロビシン)の3剤のみが、挙げられます。 - 淋菌にはクラミジアにも効果がある、アジスロマイシンは有効ですか。
-
アジスロマイシン(ジスロマック)は、主に、クラミジアの治療薬として用いられいます。
淋菌への適応としてアジスロマイシン2g製剤が発売されましたが、臨床試験は行われておらず、治療効果は不明なところがありますが、高い有効率を示す結果も得られています。
しかし、アジスロマイシンにも耐性化傾向がある淋菌の存在が知られつつあります。 - 男性の淋菌性尿道炎では、必ず症状が出ますか。
-
男性の場合、淋菌感染した後、2~7日の潜伏期を経て、排尿痛や尿道分泌物の症状が現れます。
放置してしばらくすると、それらの症状が自然に収まることもありますが、治癒したわけではなく淋菌の感染は続いています。
症状は個人差もあり、排尿痛のみの場合や、ほとんど無症状の場合もあり、相手に感染させてしまう原因にもなります。 - 性器淋菌は自然治癒しますか。また、放置するとどうなりますか。
-
一度感染が成立した淋菌は、抗生剤で治療しない限り、治癒することはありません。
治療せずに放っておくと、女性では子宮頸部から腹腔内へと淋菌感染が進行して行き、子宮付属器炎や骨盤内炎症性疾患を発症し、不妊症の原因にもなります。
男性では、前立腺炎や精巣上体炎を引き起こします。 - 淋菌は弱い菌なので、郵送中に死んでしまい検出されない可能性はありますか。
- 淋菌検査のうちの培養法の場合、淋菌が生きていないと培養されずに検出できないため郵送検査には適していませんが、当社の淋菌検査で採用している核酸増幅法(SDA法)は採取された検体中に存在する死んでしまった淋菌も検出することができます。つまり菌の生死にかかわらず検出することができます。
- 性器淋菌は、オーラルセックスでの感染の危険はありますか。
-
感染の危険性は十分あります。
淋菌は精液や腟分泌液にも存在しており、精液や腟分泌液が直接口腔粘膜に入ることから、感染の危険があります。
淋菌検査を含む、おすすめ検査








